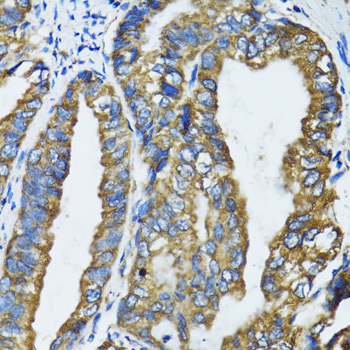
product-image-AAA174347_IHC11.jpg

Ubiquitin-like modifier-activating enzyme ATG7 (ATG7) Recombinant Protein | ATG7 recombinant protein
Recombinant Human Ubiquitin-like modifieractivating enzyme ATG7 (ATG7) Protein
Gene Names
ATG7; GSA7; APG7L; APG7-LIKE
Reactivity
Human
Purity
> 90 % as determined by SDS-PAGE.
Synonyms
Ubiquitin-like modifier-activating enzyme ATG7 (ATG7); N/A; Recombinant Human Ubiquitin-like modifieractivating enzyme ATG7 (ATG7) Protein; APG7L; GSA7; ATG12-activating enzyme E1 ATG7; Ubiquitin-activating enzyme E1-like protein.; ATG7 recombinant protein
Host
E. coli
Reactivity
Human
Purity/Purification
> 90 % as determined by SDS-PAGE.
Form/Format
PBS (58 mM Na2HPO4, 17 mM NaH2PO4, 68 mM NaCl, 5% trehalose, pH 7.4) added with 300 mM Imidazole and 15% glycerol.
Concentration
0.4 mg/mL (varies by lot)
Sequence Positions
293-563
Sequence
AFSPDCPKAVGWEKNQKGGMGPRMVNLSECMDPKRLAESSVDLNLKLMCWRLVPTLDLDKVVSVKCLLLGAGTLGCNVARTLMGWGVRHITFVDNAKISYSNPVRQPLYEFEDCLGGGKPKALAAADRLQKIFPGVNARGFNMSIPMPGHPVNFSSVTLEQARRDVEQLEQLIESHDVVFLLMDTRESRWLPAVIAASKRKLVINAALGFDTFVVMRHGLKKPKQQGAGDLCPNHPVASADLLGSSLFANIPGYKLGCYFC3NDVVAPGDST
Species
Human
Source
Human
Endotoxin level
Please contact us for more information.
Protein Residues
with N-terminal 6* His-tag.
Usage
ATG7 Protein - Centrifuge the standard vial at 6000-10000rpm for 30s.
Preparation and Storage
Storage: Store it under sterile conditions at -20°C upon receiving. Recommend to aliquot the protein into smaller quantities for optimal storage.
**Avoid repeated freeze-thaw cycles.**
Stability: The recombinant protein is stable for up to 12 months from date of receipt at -80°C.
**Avoid repeated freeze-thaw cycles.**
Stability: The recombinant protein is stable for up to 12 months from date of receipt at -80°C.
Related Product Information for ATG7 recombinant protein
ATG7 was identified based on homology to Pichia pastoris GSA7 and Saccharomyces cerevisiae APG7. In the yeast, the protein appears to be required for fusion of peroxisomal and vaculuolar membranes. The protein shows homology to the ATP-binding and catalytic sites of the E1 ubiquitin activating enzymes. The deduced 703-amino acid protein contains a central putative E1-like ATP-binding site (GxGxxG), conserved charged amino acids flanking the GxGxxG motif, and a putative E1 active site with a conserved catalytic cysteine. APG7L shares similarity with the E1 enzymes UBA2 and UBA3 (UBE1C), and it shares 38% identity with yeast Apg7. EST database analysis indicated that APG7L is expressed by many diverse tissues.
NCBI and Uniprot Product Information
NCBI GI #
NCBI GeneID
NCBI Accession #
NCBI GenBank Nucleotide #
Molecular Weight
Predicted MW: 36 kDa
Observed MW: 36 kDa
Observed MW: 36 kDa
NCBI Official Full Name
ubiquitin-like modifier-activating enzyme ATG7 isoform c
NCBI Official Synonym Full Names
autophagy related 7
NCBI Official Symbol
ATG7
NCBI Official Synonym Symbols
GSA7; APG7L; APG7-LIKE
NCBI Protein Information
ubiquitin-like modifier-activating enzyme ATG7
UniProt Protein Name
Ubiquitin-like modifier-activating enzyme ATG7
UniProt Gene Name
ATG7
UniProt Synonym Gene Names
APG7L; APG7-like; hAGP7
Customer Reviews
Loading reviews...
Share Your Experience
Similar Products
Product Notes
The ATG7 atg7 (Catalog #AAA55978) is a Recombinant Protein produced from E. coli and is intended for research purposes only. The product is available for immediate purchase. The immunogen sequence is 293-563. The Recombinant Human Ubiquitin-like modifieractivating enzyme ATG7 (ATG7) Protein reacts with Human and may cross-react with other species as described in the data sheet. The amino acid sequence is listed below: AFSPDCPKAV GWEKNQKGGM GPRMVNLSEC MDPKRLAESS VDLNLKLMCW RLVPTLDLDK VVSVKCLLLG AGTLGCNVAR TLMGWGVRHI TFVDNAKISY SNPVRQPLYE FEDCLGGGKP KALAAADRLQ KIFPGVNARG FNMSIPMPGH PVNFSSVTLE QARRDVEQLE QLIESHDVVF LLMDTRESRW LPAVIAASKR KLVINAALGF DTFVVMRHGL KKPKQQGAGD LCPNHPVASA DLLGSSLFAN IPGYKLGCYF C3NDVVAPGD ST. It is sometimes possible for the material contained within the vial of "Ubiquitin-like modifier-activating enzyme ATG7 (ATG7), Recombinant Protein" to become dispersed throughout the inside of the vial, particularly around the seal of said vial, during shipment and storage. We always suggest centrifuging these vials to consolidate all of the liquid away from the lid and to the bottom of the vial prior to opening. Please be advised that certain products may require dry ice for shipping and that, if this is the case, an additional dry ice fee may also be required.Precautions
All products in the AAA Biotech catalog are strictly for research-use only, and are absolutely not suitable for use in any sort of medical, therapeutic, prophylactic, in-vivo, or diagnostic capacity. By purchasing a product from AAA Biotech, you are explicitly certifying that said products will be properly tested and used in line with industry standard. AAA Biotech and its authorized distribution partners reserve the right to refuse to fulfill any order if we have any indication that a purchaser may be intending to use a product outside of our accepted criteria.Disclaimer
Though we do strive to guarantee the information represented in this datasheet, AAA Biotech cannot be held responsible for any oversights or imprecisions. AAA Biotech reserves the right to adjust any aspect of this datasheet at any time and without notice. It is the responsibility of the customer to inform AAA Biotech of any product performance issues observed or experienced within 30 days of receipt of said product. To see additional details on this or any of our other policies, please see our Terms & Conditions page.Item has been added to Shopping Cart
If you are ready to order, navigate to Shopping Cart and get ready to checkout.